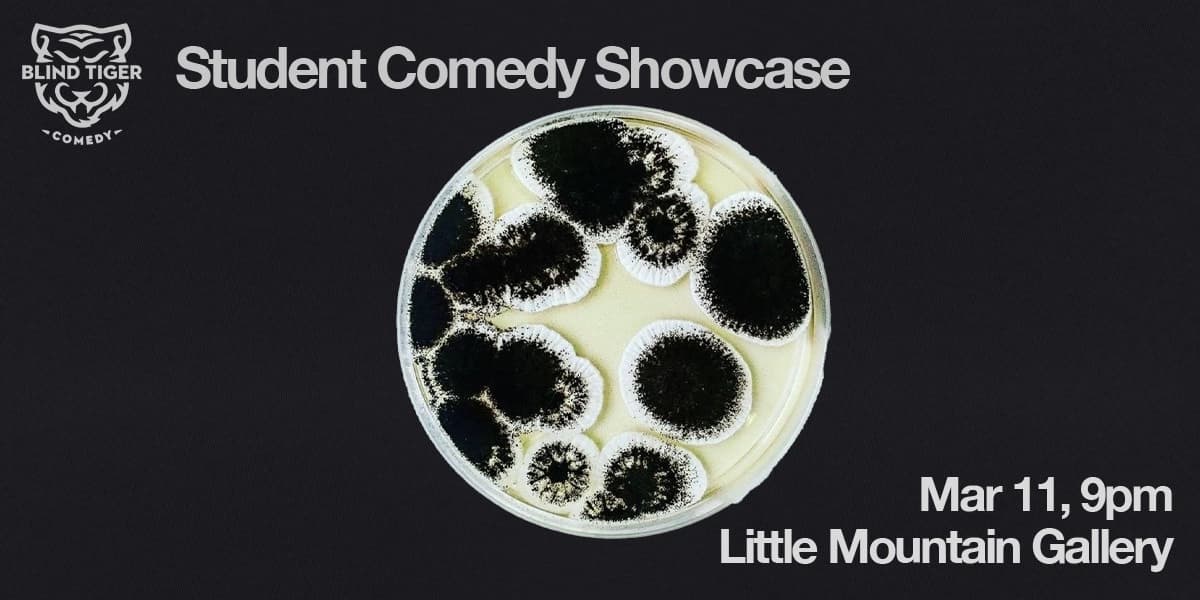
Blind Tiger Student Showcase at Little Mountain Gallery

Blind Tiger Student Showcase
Thursday, March 12, 2026
9pm
Little Mountain Gallery
Genres
Performing ArtsCommunity Events
Tickets0 interested
Event Description
Blind Tiger Comedy student showcases are a very good time. You’re going to see some very funny students throwing down their new comedy skills. You’re going to enjoy a cameo from the pros who have been teaching those students. And heck, you might even get curious about getting on stage yourself someday…To learn more or get involved yourself, visit www.blindtigercomedy.ca Check out our classes. Follow us on Instagram. This show will be presented in the Salazar Stage (Main floor) . This show is produced and curated under a rental model, independent of Little Mountain Gallery. If you have questions or comments on this performance please contact the producer justin@blindtigercomedy.ca Accessibility Please note that the venue has two separate spaces, upstairs and downstairs. All show listings should indicate which room they’re in on the description. Please ensure you note the location as both spaces do not have the same level of accessibility. The front entrance has power assisted doors. There’s a powered lift from street level to the main performance space. The venue has six private washrooms on the main floor, one of which is fully accessible with a power assisted door. The theatre doors to the main space are not power assisted at this time. The second floor is not accessible and is up two flights of stairs. We encourage patrons requiring wheelchair seating message us ahead of performances so we can arrange seating at programming@littlemountaingallery.ca

Blind Tiger Student Showcase
Genres
Performing ArtsCommunity Events
Event Description
Blind Tiger Comedy student showcases are a very good time. You’re going to see some very funny students throwing down their new comedy skills. You’re going to enjoy a cameo from the pros who have been teaching those students. And heck, you might even get curious about getting on stage yourself someday…To learn more or get involved yourself, visit www.blindtigercomedy.ca Check out our classes. Follow us on Instagram. This show will be presented in the Salazar Stage (Main floor) . This show is produced and curated under a rental model, independent of Little Mountain Gallery. If you have questions or comments on this performance please contact the producer justin@blindtigercomedy.ca Accessibility Please note that the venue has two separate spaces, upstairs and downstairs. All show listings should indicate which room they’re in on the description. Please ensure you note the location as both spaces do not have the same level of accessibility. The front entrance has power assisted doors. There’s a powered lift from street level to the main performance space. The venue has six private washrooms on the main floor, one of which is fully accessible with a power assisted door. The theatre doors to the main space are not power assisted at this time. The second floor is not accessible and is up two flights of stairs. We encourage patrons requiring wheelchair seating message us ahead of performances so we can arrange seating at programming@littlemountaingallery.ca
Diggin' the vibe of this event?
Similar events you might like
Based on your interests
Recommended for you
Sign up for a free account to get personalized event recommendations
.png&w=3840&q=75)
